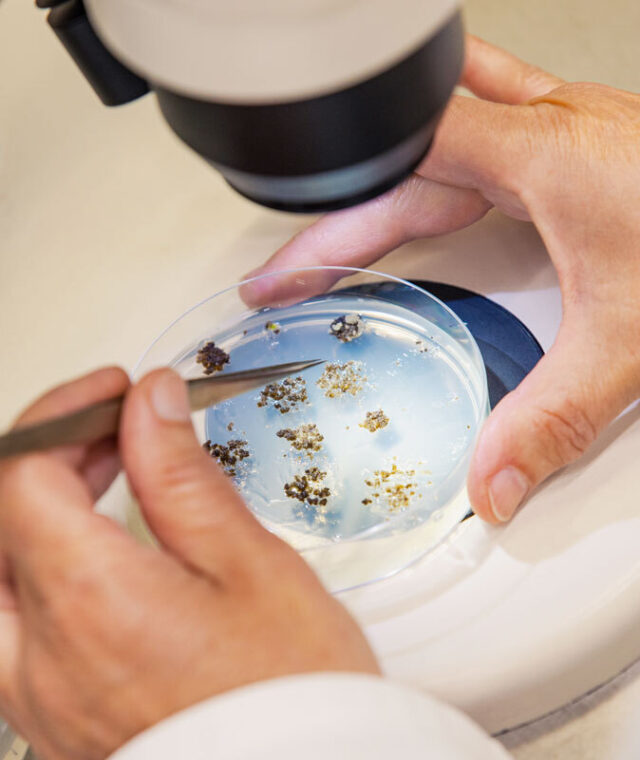

Klaus Schmidt
Eureka!
Since Klaus Schmidt wrote his doctoral dissertation at KWS 23 years ago, he has witnessed all the advances in biotechnology. The methods have changed, but the motivation has remained: to produce better plants by intervening in biological processes.
Klaus Schmidt is in the same situation as many people in research and development at KWS: It is often years before he sees the result of his labor. That was also the case when his team applied a new technology to wheat for the first time in order to confirm the trait of a gene for an application in the development of hybrid wheat. “The brief was: We need to know in three years if it has worked.”
The wheat was about to flower. Klaus Schmidt looked into the greenhouse on a Friday afternoon. He had a good feeling. “But I couldn’t stand by and wait for hours,” he says with a grin. So he waited until after the weekend. When he returned on the Monday, the wheat had indeed begun to flower, exhibiting the desired trait: The plants were to be male-sterile, meaning they could not produce pollen. “Those are the eureka moments in my work,” says the beaming 51-year-old.
From the gene to the new plant
When Klaus Schmidt talks about these technologies, technical terms such as “transgenic,” “genome editing” and “doubled haploid” crop up. They refer to processes that are only possible with the appropriate know-how and technical equipment. “For example, research provides us with a prepared candidate gene that might be responsible for fungal resistance.” Using conventional and modern methods, the biotechnologists then intervene selectively in biological processes – and can confirm that supposition in the best-case scenario.
Sometimes, however, the identified gene is not responsible for the trait after all. “You need a high degree of frustration tolerance in our job.” Especially since biotechnology is one link in a chain of services. “If there are delays somewhere, that has a domino effect on the planning of the others.”
Explanation of terms
The biotechnology methods mentioned above
Transgenic method
With the aid of the conventional transgenic method, individual genes or sections of DNA previously found in other organisms can be incorporated into the genome of crops and thus transferred in a pinpointed manner. The result is a plant with a foreign gene (a transgene). It is also possible to turn certain genes off. The method in detail.
Genome editing
Genome editing is one of the modern methods of plant breeding and offers additional means of improving plants in a targeted way. Depending on their application, some of the methods can produce genetically modified plants. Genome editing can be used to achieve breeding goals faster and more precisely than in the past, as a result of which genetic variation can be expanded so as to increase varietal diversity. An example: If the trait of a gene in a plant is known or there is supposition about a trait, that gene can be turned off to test that hypothesis. If the plant then loses its trait, the suspected gene is responsible for that trait. The method in detail.
Doubled haploid method
Conventional breeding methods use repeated self-pollination to obtain homozygous lines that produce progeny with the same genetic makeup. However, this takes seven to eight generations. With the doubled haploid method, this can be achieved in a single generation: Plant cells that carry only one set of chromosomes, i.e. are haploid, are isolated and cultivated. Haploid plantlets are produced from them and are used to obtain homozygous plants after the set of chromosomes has been doubled. The method in detail.
Progress in 23 years
Klaus Schmidt has been doing this job for KWS for 23 years now. Back then, he was given the opportunity to write his doctoral dissertation at PLANTA, as our department of applied plant genetics and biotechnology used to be called. “I previously trained as an agricultural technical assistant and worked in plant breeding at a sugarbeet breeder. Then I started studying and simply submitted an unsolicited application to KWS afterwards.” It was also a stroke of luck geographical speaking: Klaus Schmidt hails from a village about an hour north of Einbeck, where he played handball, is now married and has two children, and is an active church member. He was therefore able to stay where he had been born and raised.
If you have been with a company for so long, you naturally see what changes there have been. One example: Klaus Schmidt needed the gene from a desert plant to write his dissertation. He had found literature on it. “I therefore had to find out: Does this plant grow somewhere in a botanical garden so that I can extract DNA from it?” But when he needs such DNA now, he simply orders it on the Internet. “It’s amazing what’s possible with bioinformatics today.”
Biotechnological processes have also evolved and changed. “My subject area has expanded in the past five years to include doubled haploid technology. Without it, efficient breeding is not even feasible now for many plants.”
And there will be no end to the advances: Klaus Schmidt sees a lot of potential in artificial intelligence to enable decisions to be made at an early stage with the aid of automatic image recognition. “One of our objectives is to be able to investigate the function of genes at the cell level so that analyses and assays that are currently carried out in the greenhouse can be performed in the test tube.” And finding totally new methods is also one of the goals of biotechnology.

Klaus Schmidt and David Pacheco-Villalobos, Senior Scientist Cell Biology, discussing a transformation experiment.
This tissue is called sugarbeet callus.

These corn plants were created using the transgenic method. They are moved from the culture room to the greenhouse.
Successful cooperation
In turn, Klaus Schmidt values the dialogue with other scientists and joint projects with external parties. “We have successful partnerships with Wageningen University, for example, allowing us to keep our finger on the pulse of things. Another option is to participate in publicly funded projects. That’s where universities often approach us, because we can put research results into practice.”
Working with outsiders is also a balancing act for our biotechnologists, explains Klaus Schmidt: “We scientists need to present our findings, otherwise there’s no way of sharing and discussing scientific advances. However, there are always tricky situations: What can you disclose, and which findings do you have to keep to yourself because they’re KWS’ intellectual property?”
The changing face of work
Klaus Schmidt’s working group has now grown to 35 people. A working group in St. Louis is also part of his team. Klaus Schmidt’s own work has changed as a result of his being responsible for staff in his role as group leader: Whereas he used to conduct experiments himself, team leadership duties now take up most of his time. “I sometimes miss playing an active part – there’s still very much a scientist in my heart.” Instead of working with cultures himself, he now occasionally goes to the culture room or the greenhouse to look around. “‘I bet you go there every Friday evening,’ people have told me in jest,” says Klaus Schmidt, grinning again. |
This article is from insideKWS, the employee magazine of KWS. If you are an employee of our company, you have access to all other articles and previous issues.
© KWS SAAT SE & Co. KGaA 2025